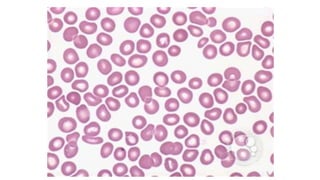

This document provides an overview of hemostasis and approaches to bleeding. It reviews the four major events of hemostasis - primary hemostasis, secondary hemostasis, fibrin clot formation and stabilization, and inhibition of coagulation. Specific bleeding disorders are discussed including von Willebrand disease, hemophilia A/B, and liver disease. A systematic approach is outlined for evaluating and managing patients with bleeding including history, physical exam, investigations, and targeted hemostatic therapy. Specific management strategies are discussed for warfarin reversal, hemophilia, and immune thrombocytopenia.